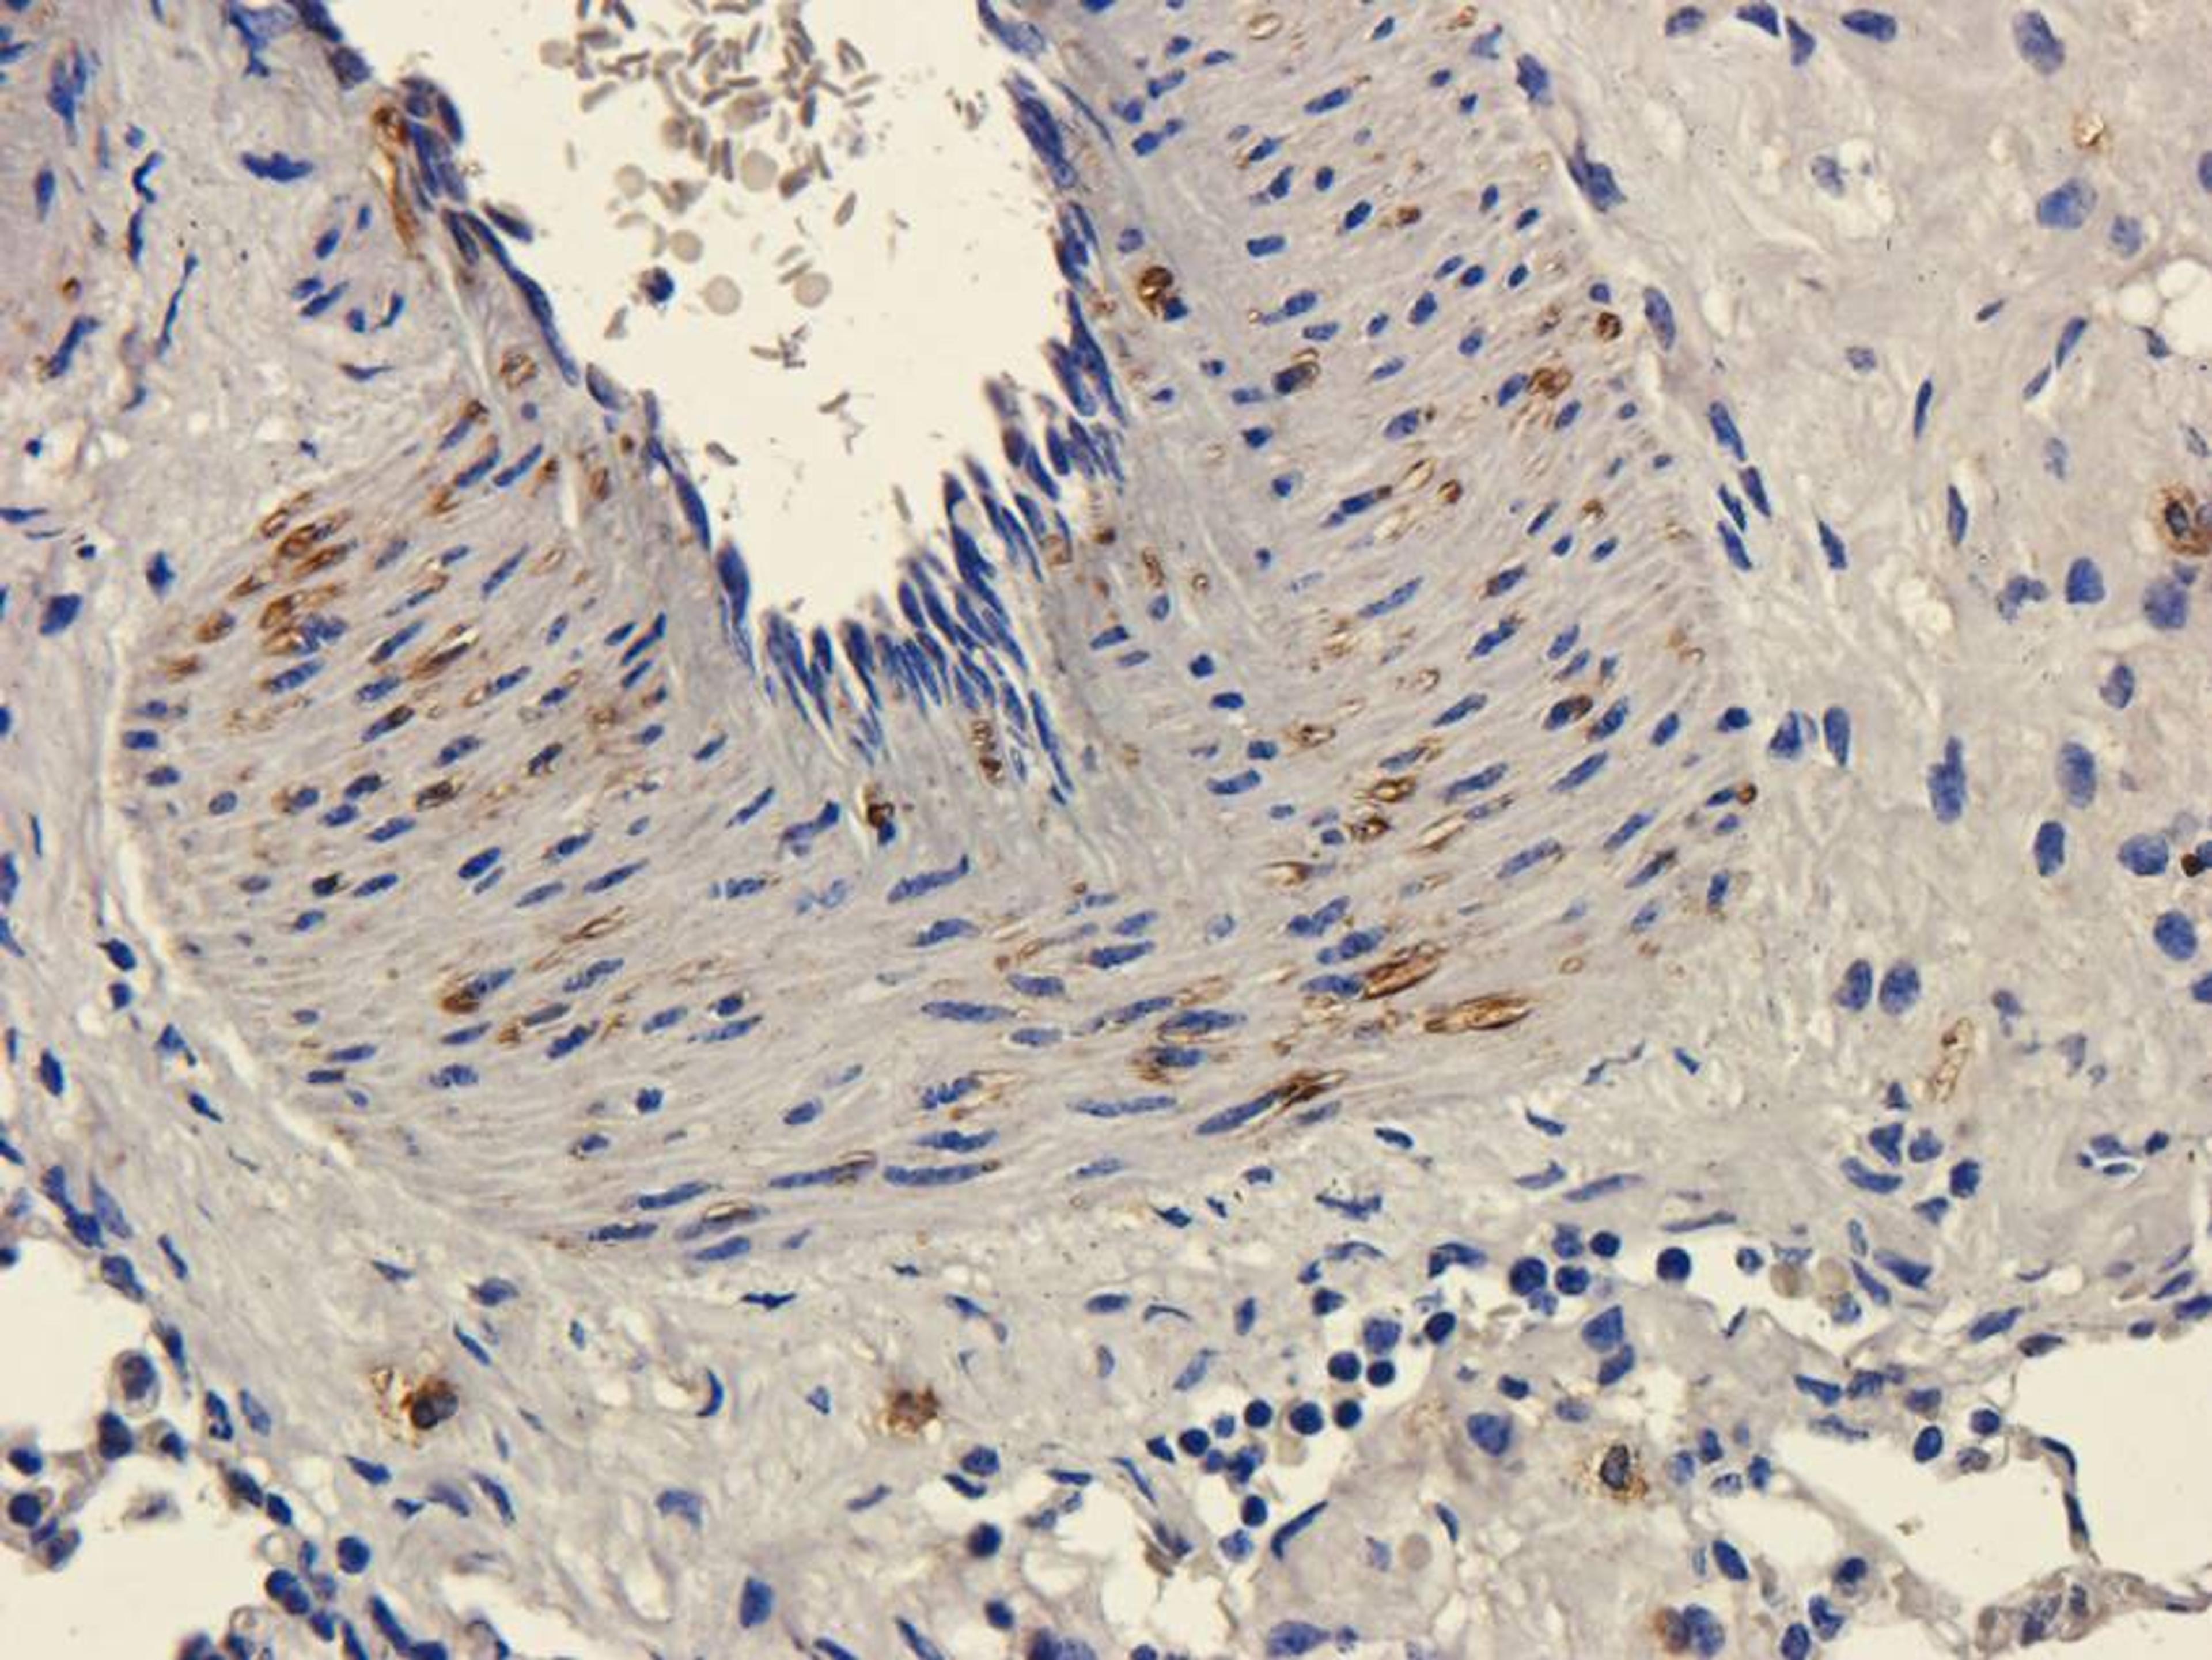
Immunohistochemical staining of guinea pig lung tissue using anti-CD11c (dilution of primary antibody - 2.5 ug/ml)

Product & ReviewsAntibodies
CD11c antibody
Product Details
- Cat. No.
- orb13554
- Type
- Primary Antibody
- Clonality
- Polyclonal
- Host
- Rabbit

The supplier does not provide quotations for this antibody through SelectScience. You can search for similar antibodies in our Antibody Directory.
Description
Rabbit polyclonal antibody to CD11c
Biological Information
- Clonality: Polyclonal
- Host: Rabbit
- Reactivity: Guinea Pig, Human, Mouse, Rat
- Clone: NULL
- Conjugate: Unconjugated
- Isotype: IgG
- Gene: 3687
Handling
- Quantity: 100 ?g; 200 ?g
- Storage: Store at 4°C for up to two weeks. For long term storage; aliquot and store at -20°C; avoid freeze/thaw cycles.
- Buffer: 10 mM PBS; 0.02% sodium azide
Applications
- Immunofluorescence (IF)
- Immunohistochemistry (Paraffin-Embedded Sections) (IHC (P))
- Western Blotting (WB)